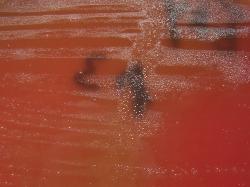
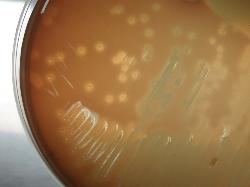

Ecology
| Erysipelothrix rhusiopathiae |
| Gram-stained Erysipelothrix rhusiopathiae from broth culture - left and from BHI agar - right |
| Erysipelothrix rhusiopathiae colonies on Sheep Blood Agar after 1 week anaerobic incubation |
Taxonomy
Morphology
Cultural characteristics
Biochemical characters
Pathogenicity
References
Phylum Bacillota (Firmicutes), Class Erysipelotrichia, Order Erysipelothrichales, Family Erysipelotrichaceae, Genus Erysipelothrix,
Erysipelothrix rhusiopathiae (Migula 1900) Buchanan 1918.
Historical synonyms: Bacillus insidiosus Trevisan 1885, Bacillus rhusiopathiae suis Kitt 1893, Bacterium rhusiopathiae Migula 1900,
Erysipelothrix porci Rosenbach 1909, Erysipelothrix erysipeloides Rosenbach 1909, Erysipelothrix murisepticus Rosenbach 1909,
Erysipelothrix insidiosa (Trevisan 1885) Langford and Hansen 1953.
Erysipelothrix rhusiopathiae (Migula 1900) Buchanan 1918.
Historical synonyms: Bacillus insidiosus Trevisan 1885, Bacillus rhusiopathiae suis Kitt 1893, Bacterium rhusiopathiae Migula 1900,
Erysipelothrix porci Rosenbach 1909, Erysipelothrix erysipeloides Rosenbach 1909, Erysipelothrix murisepticus Rosenbach 1909,
Erysipelothrix insidiosa (Trevisan 1885) Langford and Hansen 1953.
Gram-positive (decolorize easily), straight or slightly curved, slender rods, 0.2-0.6 x
0.5-3.0 µm, with a tendency to form long filaments (up to 60 µm); occuring singly, in
short chains, in pairs at an angle to give V-forms, or in groups with no particular
arrangement. Nonspore-forming. Nonmotile. Noncapsulated. Cells in smooth
colonies (S-form) are short, slender, straight or slightly curved rods; in rough colonies
(R-form), cells vary from short forms to long, filamentous structures and thick rods
may be present singly, in chains or in entangled masses. L-forms have been
described.
0.5-3.0 µm, with a tendency to form long filaments (up to 60 µm); occuring singly, in
short chains, in pairs at an angle to give V-forms, or in groups with no particular
arrangement. Nonspore-forming. Nonmotile. Noncapsulated. Cells in smooth
colonies (S-form) are short, slender, straight or slightly curved rods; in rough colonies
(R-form), cells vary from short forms to long, filamentous structures and thick rods
may be present singly, in chains or in entangled masses. L-forms have been
described.
Smooth form colonies are small (0.3-1.5 mm in diameter in 24-48 hours), convex,
transparent with smooth, glistening surface; in time, the colonies become slightly
larger and the center becomes opaque. R-form colonies are larger, flatter, and more
opaque; the surface is matt and the edge irregular. The cell morphology varies in
some limits with the growth medium and conditions of incubation: pH 7.6-8.2 and 33
ºC favors the S-form while at pH bellow 7.0 and at 37 ºC the R-form predominates.
Intermediate forms may exist. S-form colonies dissociate to intermediate and R-form
colonies, while R-forms may give rise to S-form colonies.
Growth in nutrient agar is improved by the addition of glucose (0.2-0.5% w/v) or serum
(5-10% v/v); grows well in blood and chocolate agar in 5-10% CO2.
Organic growth factors are required (several amino acids, riboflavin), tryptophan
enhanced growth and oleic acid is also required. Alpha-hemolitic. Beta-hemolysis is
not produced. Grow at/on: pH 6.7-9.2 (optimum pH 7.2-7.6). Temperature range 5-42
ºC (optimum 30-37 ºC). No growth in 8.5% NaCl medium. Facultatively anaerobic,
microaerophilic on isolation, but lab cultures grow well aerobically and anaerobically;
growth is improved by 5-10% CO2 .
transparent with smooth, glistening surface; in time, the colonies become slightly
larger and the center becomes opaque. R-form colonies are larger, flatter, and more
opaque; the surface is matt and the edge irregular. The cell morphology varies in
some limits with the growth medium and conditions of incubation: pH 7.6-8.2 and 33
ºC favors the S-form while at pH bellow 7.0 and at 37 ºC the R-form predominates.
Intermediate forms may exist. S-form colonies dissociate to intermediate and R-form
colonies, while R-forms may give rise to S-form colonies.
Growth in nutrient agar is improved by the addition of glucose (0.2-0.5% w/v) or serum
(5-10% v/v); grows well in blood and chocolate agar in 5-10% CO2.
Organic growth factors are required (several amino acids, riboflavin), tryptophan
enhanced growth and oleic acid is also required. Alpha-hemolitic. Beta-hemolysis is
not produced. Grow at/on: pH 6.7-9.2 (optimum pH 7.2-7.6). Temperature range 5-42
ºC (optimum 30-37 ºC). No growth in 8.5% NaCl medium. Facultatively anaerobic,
microaerophilic on isolation, but lab cultures grow well aerobically and anaerobically;
growth is improved by 5-10% CO2 .
Widely distributed in nature (soil, surface waters of farms, sewage effluent of abattoirs
parasitic on mammals, birds and fish. Some strains may be pathogenic for mammals
and birds.
It has been isolated, not in association with infection, from the surfaces of fish,
shellfish, fish slime, and fish boxes, cephalopods, crustaceans, including oysters and
lobsters, from salted or pickled bacon after several weeks, and from ham 3 months
after smoking.
Isolated from bovine tonsils.
Heat and direct sunlight diminish its viability.
A low temperature, alkaline conditions, and organic matter favor its survival. Survive in the dried state for many years. Does not survive
heating at 60 ºC for 15 minutes.
Of the minimum 23 serovars which exist, serovars 1 and 2 are the most common.
Bacteriophages have been isolated and lysogeny has been reported.
Resistant to sulphonamides, colistin, gentamicin, kanamycin, neomycin, novobiocin and polymyxin. Sensitive to penicillin, ampicillin,
streptomycin, chloramphenicol and tetracycline.
Grows in the presence of phenol (0.2% w/v), potassium tellurite (0.05% w/v), sodium azide (0.1% w/v), thallous acetate (0.02% w/v),
2,3,5-triphenyltetrazolium chloride (0.2% w/v), and crystal violet (0.001% w/v).
parasitic on mammals, birds and fish. Some strains may be pathogenic for mammals
and birds.
It has been isolated, not in association with infection, from the surfaces of fish,
shellfish, fish slime, and fish boxes, cephalopods, crustaceans, including oysters and
lobsters, from salted or pickled bacon after several weeks, and from ham 3 months
after smoking.
Isolated from bovine tonsils.
Heat and direct sunlight diminish its viability.
A low temperature, alkaline conditions, and organic matter favor its survival. Survive in the dried state for many years. Does not survive
heating at 60 ºC for 15 minutes.
Of the minimum 23 serovars which exist, serovars 1 and 2 are the most common.
Bacteriophages have been isolated and lysogeny has been reported.
Resistant to sulphonamides, colistin, gentamicin, kanamycin, neomycin, novobiocin and polymyxin. Sensitive to penicillin, ampicillin,
streptomycin, chloramphenicol and tetracycline.
Grows in the presence of phenol (0.2% w/v), potassium tellurite (0.05% w/v), sodium azide (0.1% w/v), thallous acetate (0.02% w/v),
2,3,5-triphenyltetrazolium chloride (0.2% w/v), and crystal violet (0.001% w/v).
Most frequently it is found in pigs where it is the causative agent of the economically important disease, swine erysipelas (serotypes
1a, 1b and 2). Cause endocarditis in dogs, polyarthritis in lambs and calves, septicemia in turkeys and ducks, septicaemia and
urticaria in dolphins, and cutaneous lesions in humans. Natural infections, with epizootics, also occur in other domestic animals
(sheep, lambs, cows, horses, dogs, and mice) and birds (turkeys, chickens, geese, and pheasants) and also in wild and zoo
animals.
In man (veterinarians, butchers, fish handlers) it causes a skin infection, erysipeloid of Rosenbach; rarely the infection become
systemic, causing arthritis and endocarditis, so it is an incidental zoonotic infection of man. The bacteraemia may be complicated by
abscess in other organs, glomerulonephritis, and central nervous system infection, including meningitis and brain abscess.
Pathogenic for mouse.
Isolated from the lung and intestine of a diseased blue penguin.
Most strains produce hyaluronidase, probably associated with virulence and serovar 1.
Neuraminidase is produced in differing amounts.
A capsule-like structure confers resistance to phagocytosis.
1a, 1b and 2). Cause endocarditis in dogs, polyarthritis in lambs and calves, septicemia in turkeys and ducks, septicaemia and
urticaria in dolphins, and cutaneous lesions in humans. Natural infections, with epizootics, also occur in other domestic animals
(sheep, lambs, cows, horses, dogs, and mice) and birds (turkeys, chickens, geese, and pheasants) and also in wild and zoo
animals.
In man (veterinarians, butchers, fish handlers) it causes a skin infection, erysipeloid of Rosenbach; rarely the infection become
systemic, causing arthritis and endocarditis, so it is an incidental zoonotic infection of man. The bacteraemia may be complicated by
abscess in other organs, glomerulonephritis, and central nervous system infection, including meningitis and brain abscess.
Pathogenic for mouse.
Isolated from the lung and intestine of a diseased blue penguin.
Most strains produce hyaluronidase, probably associated with virulence and serovar 1.
Neuraminidase is produced in differing amounts.
A capsule-like structure confers resistance to phagocytosis.
- Stackebrandt E., 2009. Genus I. Erysipelothrix Rosenbach 1909. In: (Eds.) P.D. Vos, G. Garrity, D. Jones, N.R. Krieg, W. Ludwig, F.
A. Rainey, K.-H. Schleifer, W.B. Whitman. Bergey’s Manual of Systematic Bacteriology, Volume 3: The Firmicutes, Springer, 1299-
1306. - Schlech W.F., 2005. Erysipelothrix. In: Topley & Wilson’s Microbiology & Microbial Infections, 10th Edition, Edited by Borriello S.P.,
Murray P.R. and Funke G., Bacteriology, volume 2, 970-976.
Positive results for H2S production in TSI, neuraminidase, acid production from:
N-acetylglucosamine, dextrin, fructose, galactose, glucose, lactose, maltose,
mannose (weak) and sucrose (weak). Can utilize: L-arabinose, D-fructose,
N-acetyl-D- mannosamine and D-galactose.
Negative results for aminopeptidase, catalase, casein hydrolysis, cellulose
hydrolysis, esculin hydrolysis, gelatin hydrolysis, beta-glucosidase, hippurate
hydrolysis, indole production, methyl-red, nitrates reduction to nitrites, oxidase, starch
hydrolysis, Tween 20, 40, 60 hydrolysis, urea hydrolysis, Voges-Proskauer, acid
production from: adonitol, amygdalin, arbutin, arabinose, cellobiose, dulcitol,
erythritol, esculin, fucose, beta-gentiobiose, glycerol, glycogen, inositol, inulin, lyxose,
mannitol, melezitose, melibiose, n-methyl-D-mannoside, alpha-methyl-D-glucoside,
raffinose, rhamnose, salicin, sorbitol, sorbose, starch, tagatose, trehalose, turanose,
xylitol and xylose.
No utilization of: arbutin, cellobiose, gentiobiose, glycerol, salicin and D-trehalose.
Variable results for alkaline phosphatase and lecithinase.
N-acetylglucosamine, dextrin, fructose, galactose, glucose, lactose, maltose,
mannose (weak) and sucrose (weak). Can utilize: L-arabinose, D-fructose,
N-acetyl-D- mannosamine and D-galactose.
Negative results for aminopeptidase, catalase, casein hydrolysis, cellulose
hydrolysis, esculin hydrolysis, gelatin hydrolysis, beta-glucosidase, hippurate
hydrolysis, indole production, methyl-red, nitrates reduction to nitrites, oxidase, starch
hydrolysis, Tween 20, 40, 60 hydrolysis, urea hydrolysis, Voges-Proskauer, acid
production from: adonitol, amygdalin, arbutin, arabinose, cellobiose, dulcitol,
erythritol, esculin, fucose, beta-gentiobiose, glycerol, glycogen, inositol, inulin, lyxose,
mannitol, melezitose, melibiose, n-methyl-D-mannoside, alpha-methyl-D-glucoside,
raffinose, rhamnose, salicin, sorbitol, sorbose, starch, tagatose, trehalose, turanose,
xylitol and xylose.
No utilization of: arbutin, cellobiose, gentiobiose, glycerol, salicin and D-trehalose.
Variable results for alkaline phosphatase and lecithinase.
(c) Costin Stoica

| Antibiogram |
| Culture media |
| Biochemical tests |
| Stainings |
| Images |
| Movies |
| Articles |
| Identification |
| Software |
| R E G N U M PROKARYOTAE |
| Back |

| Sheep Blood Agar after 24 hours incubation |